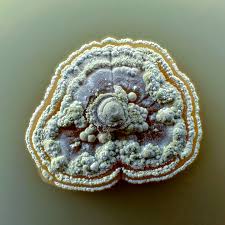
imagen del hongo

Antrarida y su mundo FUNGI
Cryomyces antarcticus
Un hongo extremófilo que vive incrustado en rocas del desierto polar antártico. Soporta frío extremo, alta radiación UV y casi ausencia de agua. Prefiere grietas de rocas oscuras donde la nieve se derrite mínimamente.
Ecológicamente, es una prueba viviente de resistencia, y su existencia sirve para estudios astrobiológicos. No tiene usos gastronómicos ni medicinales tradicionales.

Pseudogymnoascus pannorum
Aparece en suelos helados, cuevas y zonas costeras antárticas. Sobrevive a temperaturas bajo cero y períodos prolongados sin nutrientes.
Actúa como descomponedor de restos orgánicos en un ecosistema donde casi nada se degrada rápido. Sus enzimas son estudiadas por su potencial biotecnológico.
Phialophora fastigiata
Presente en zonas húmedas costeras de la Antártida, creciendo sobre madera flotante, suelos fríos y restos de vegetación arrastrada por corrientes oceánicas.
Contribuye a procesos de descomposición lenta pero crucial en un ambiente donde la materia orgánica escasea. Se investiga por su capacidad de producir compuestos resistentes al frío.
